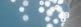

AZ ALPHA IMPLANT KFT. MÁR 15 ÉVE
AZ ÖN MEGBÍZHATÓ PARTNERE

AZ ALPHA IMPLANT KFT. MÁR 15 ÉVE
AZ ÖN MEGBÍZHATÓ PARTNERE







































Kiállítás nyitvatartása 2025. március 21., péntek: 08.30–18.00 2025. március 22., szombat: 08.30–17.00
A kétnapos rendezvény alatt közel 60 szakkiállító várja az érdeklődőket, a kiállítás megtekintése díjmentes, de regisztrációköteles.
Kongresszusi regisztráció 2025. március 21–22. reggel 8 órától. A regisztráció a szakmai programokra kötelező.
A regisztráció a Hungexpo „C” kongresszusi központ bejáratánál található.
KONGRESSZUS
2025. március 21., péntek
09.10–09.15 Dr. Volom András, Dr. Benyőcs Gergely: Megnyitó
09.15–10.15 Dr. Gerlóczy Pál: A fémmentes indirekt restaurációk adhezív ragasztása
10.15–11.45 Dr. Piotr Puchała Gyökércsatornák előkészítésének, fertőtlenítésének és lezárásának modern megközelítései
11.45–12.00 Kávészünet
12.00–13.00 Dr. Mustafa Al-Qassab:
Endodontikusan kezelt fogak helyreállítása szubgingivalis szélekkel: a fogászati implantátumok előtti utolsó reménysugár
13.00–14.30 Ebédszünet
14.30–15.30 Dr. Mustafa Al-Qassab: Matricázási stratégiák a mindennapos posterior restaurációkban
15.30–16.15 Dr. Benyőcs Gergely: Ha nem tudom, nem fáj? Meglepő anatómiai variációk, és azok ellátása a fogorvosi praxisban
16.15–16.30 Kávészünet
16.30–17.15 Dr. Götz Gergely: Csatornatranszponálás nélküli tudatos irrigáció –a sikeres endodoncia alapkövei
KONGRESSZUS
2025. március 22., szombat
09.25–09.30 Dr. Volom András, Dr. Benyőcs Gergely: Megnyitó
09.30–10.30 Dr. Bodrogi Attila: Az ezerarcú fogorvos, avagy a komprehenzív esztétika kihívásai
10.30–11.00 Kávészünet
11.00–12.30 Prof. dr. Danimir Jevremović: Cirkónia – kerámia a mindennapi használat
12.30–14.00 Ebédszünet
14.00–15.00 Dr. Kiss Vivien: Direkt anterior megoldások a mindennapokban 15.00–15.45 Dr. Fóris András, dr. Fóris Pál: Út a modern praxis felé: egy eszköz, amely szinte végtelen lehetőségeket tesz lehetővé az orvosesztétikai és a fogorvosi lézerkezelésekben
KONGRESSZUS
2025. március 21., péntek
09.20–09.25 Dr. Németh Zsolt, dr. Sidó Levente: Megnyitó
09.25–10.25 Prof. dr. Bülent Kurtis:
Az irányított biofilmterápia (GBT) protokollja az irányított csontregenerációs (GBR) technikával nyert alveoláris csontok védelmére
10.25–10.45 Kávészünet
10.45–12.30 Dr. Pedro Moura: All on X 12.30–14.00 Ebédszünet
14.00–15.15 Dr. Molnár Bálint: Periimplantaris mucositis és periimplantitis kezelésének korszerű koncepciói, kémiai plakk-kontroll szerepe a terápiában (Amikor klórhexidinre és hialuronsavra van szükség)
15.15–15.30 Kávészünet
15.30–16.30 Dr. Végh Dániel: Diabétesz és implantológia kapcsolata
16.30–17.00 Dr. Tálos Marianna: Feszes ínyképzés intelligens szövettel

YOUR WORLDWIDE NO.1 REFERENCE
OUTSTANDING QUALITY 1,2
> Strictly controlled raw material selection > Cutting-edge production
> Quality management of the final product
UNIQUE BIOFUNCTIONALITY






















KONGRESSZUS
2025. március 22., szombat
09.25–09.30 Dr. Németh Zsolt, dr. Sidó Levente: Megnyitó
09.30–11.00 Dr. Nyárády Zoltán: Dinamikus valós idejű navigáció a sebészetben –fotogrammetrikus lenyomatvétel a protetikában – X-guide segítségével
11.00–11.15 Kávészünet
11.15–12.15 Dr. Bartha Ferenc:
A postextractiós sebgyógyulás hatása a protetikailag megtervezett implantátumpozícióra 12.15–13.45 Ebédszünet
13.45–14.45 Dr. Mandel Iván: A periimplantaris gyulladások megelőzése: nem sebészi parodontalis terápia küretkanalak nélkül
14.45–15.15 Dr. Kónya János: Implantációs protetikai megoldások: tapasztalatok és innovációk

„az év intraorális szkennere” „a legjobb IOS dizájn” „az év leginnovatívabb digitális fogászati vállalata” (iDD - Institute of Digital Dentistry)
A világ első fotogrammetrikus, 0,005 mm-nél pontosabb IO szkennere
All-On-X implantációhoz – és minden máshoz is. Már Wireless kivitelben is!
Kettő-az egyben rendszer Extrém pontos


Szuper könnyű (124 g) és keskeny Fogatlan esetek könnyed szkennelése


„Percek alatt egy tökéletesen pontos All-on-X implant lenyomat. Game changer!"
(Dr. Forster András, PhD, Urban Regeneration Institute)




KONGRESSZUS
2025. március 21., péntek
09.20–09.30 Székelyhidi Éva: Megnyitó
09.30–10.10 Schmuck Andrea:
Parodontális zárt küret műszerhasználat dentálhigiénikusoknak
10.10–10.50 Mester Emese:
Fogászati mousse-ok titkai: a rendelői kezeléstől az otthoni megoldásokig
10.50–11.15 Kávészünet
11.15–12.00 Vas Henriett: 21. század – fókuszban a dentálhigiénia
12.00–12.30 Dr. Markgruber Bence:
Van, amihez a fogkefe nem elég – orálbiotikummal a szájüregi flóra egyensúlyáért
14.00–14.40 Dr. Tihanyi Dóra:
Fogköztisztítás felsőfokon – hatékony motiváció a digitális korban
14.40–15.10 Székelyhidi Éva:
Dentális edukáció – Módszertani kézikönyv (Nemzeti Népegészségügyi és Gyógyszerészeti Központ)
15.10–15.40 Csontos Ramóna: Precízió és kíméletesség: modern megoldások a fogászati higiéniában
15.40–16.00 Kávészünet
16.00–16.25 Kis-György Rita: A száj titkos ellensége: A xerostomia következményei és lehetőségei
16.25–16.50 Dr. Tóth György: A szájhigiénikusok szerepe a dohányzási ártalomcsökkentésben
16.50–18.00 MDE éves közgyűlés



SZKENNELJE
Érzékel minden mozdulatot és automatikusan igazítja az intenzitást
3



KONGRESSZUS
2025. március 22., szombat
09.25–09.30 Dr. Borbély Péter, dr. Nagy Zsolt: Megnyitó
09.30–10.15 Dr. Bajusz Örs: Digitális munkafolyamatok finomhangolása 2025-ben Magyarországon a minőség, hatékonyság és tervezhetőség összhangjában (tapasztalatok és javaslatok rendelőnk elmúlt 10 évének digitális átállása alapján)
10.15–11.00 Dr. Nagy Árpád: Digitális álmok, analóg falak, hibrid megoldások
11.00–11.20 Kávészünet
11.20–12.00 Dr. Yosef Markosz: Személyre szabott fogszabályozó készülékek
12.00–12.40 Dr. Nagy Anna: Tudatos mandibulapozicionálás a virtuális térben 12.40–14.00 Ebédszünet 14.00–16.00 Matej
Jendrichovsky: Bemutatkoznak a legújabb innovációk a restauratív munkafolyamatok és az orto-restauratív fogászat számára


Mini színpadon gyakorlati bemutatók, többféle területen
11.45–12.30 Dr. Sárossi Benedek: Mit lehet kihozni egy CT felvételből 5 másodperc alatt? Avagy: gyorsabb diagnosztika CBCT felvételből mint kisfilmes röntgenfilmről!
12.35–13.05 Albert Kristóf: Fotogrammetrikus lenyomatvétel a Shining 3D díjnyertes Aoralscan Elite szkennerével – Dinamikus harapás rögzítés egyedi állkapocs mozgással a MetiSmile arcszkennerrel
13.10–13.35 Dr. Rappensberger Csaba: Megelőzhető a fogorvos hátfájása? Igen, megfelelő ergonómiájú munkavégzésse
13.45–14.15 Dr. Mustafa Al-Qassab: Matricázási stratégiák a mindennapos posterior restaurációkban 14.20–14.50 Dr. Sárossi Benedek: Trilor üvegszálas kompozit – alternatíva a fémmentes fogászati eljárások terén
15.00–15.30 Matej Jendrichovsky: Innovációk a restauratív munkafolyamatoknál és az orto-restauratív fogászatban
15.45–16.15 Dr. Zsiga Zsolt: Csontosodás elősegítése implantátumoknál Bemer mágnesterápiás kezeléssel
11.35–12.05 Dr. Sárossi Benedek: Trilor üvegszálas kompozit – alternatíva a fémmentes fogászati eljárások terén 12.15–12.40 Domonkos Szilárd: Tippek és trükkök a Medit szkennerrel 12.45–13.15 Dr. Volom András: Kompozit polírozás porcelántól fényesebbre 13.20–13.50 Albert Kristóf: Fotogrammetrikus lenyomatvétel a Shining 3D díjnyertes Aoralscan Elite szkennerével – Dinamikus harapás rögzítés egyedi állkapocs mozgással a MetiSmile arcszkennerrel 13.55–14.20 Kiss Attila: Fogászati fotózási alapok a Sony-val 14.25–14.45 Dr. Rappensberger Csaba: Megelőzhető a fogorvos hátfájása? Igen, megfelelő ergonómiájú munkavégzéssel

Think your complex restorative procedures can't be simplified? Think again.






The new iTero Lumina™ scanner, powered by iTero Multi-Direct Capture™ technology, is designed to quickly and accurately capture a wide range of restorative procedures in a single pass.
Discover how you can unlock outstanding simplicity and schedule your demo today.
















